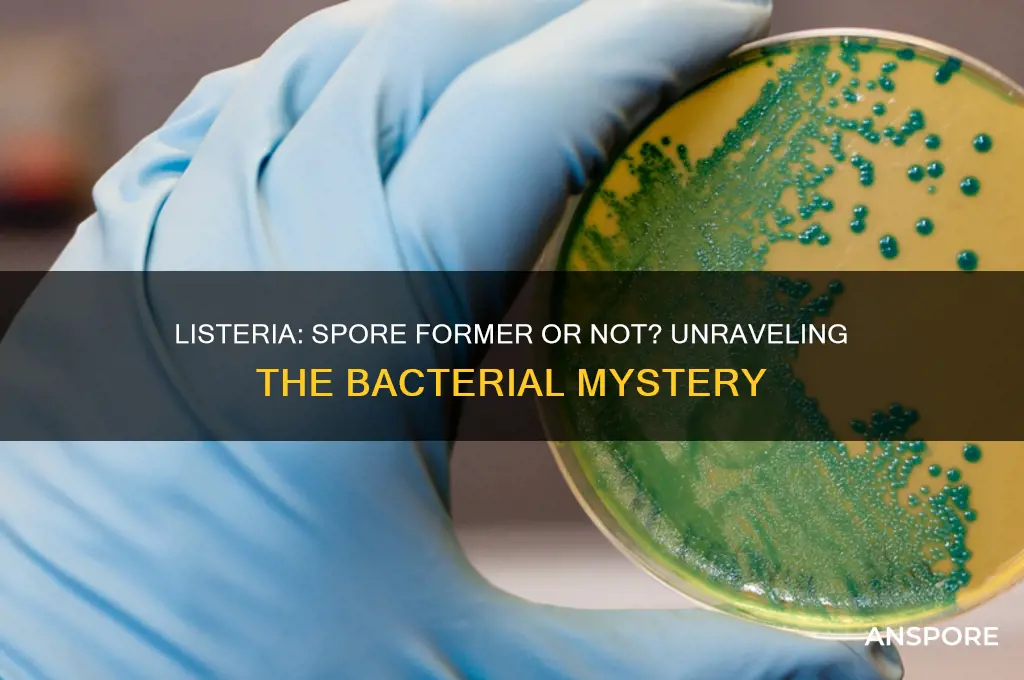
is listeria a spore forner

Listeria monocytogenes, the bacterium responsible for listeriosis, is a significant foodborne pathogen known for its ability to survive in harsh environments. However, it is important to clarify that Listeria is not a spore-former. Unlike spore-forming bacteria such as Clostridium botulinum or Bacillus cereus, which produce highly resistant spores to withstand extreme conditions, Listeria relies on other mechanisms to endure stress. These include its ability to grow at refrigeration temperatures, tolerate high salt concentrations, and form biofilms. Understanding that Listeria does not form spores is crucial for implementing effective food safety measures, as it highlights the importance of controlling temperature, hygiene, and cross-contamination to prevent its growth and spread.
What You'll Learn
- Listeria's Classification: Is Listeria monocytogenes classified as a spore-forming bacterium
- Spore Formation Process: Does Listeria undergo sporulation like Bacillus or Clostridium
- Survival Mechanisms: How does Listeria survive without forming spores
- Environmental Persistence: Can Listeria persist in harsh conditions without spores
- Food Safety Implications: Does Listeria's non-spore-forming nature affect food contamination risks

Listeria's Classification: Is Listeria monocytogenes classified as a spore-forming bacterium?
Listeria monocytogenes, a notorious foodborne pathogen, is often associated with severe infections, particularly in vulnerable populations such as pregnant women, newborns, the elderly, and immunocompromised individuals. Despite its infamy, there is a common misconception regarding its classification as a spore-forming bacterium. To clarify, Listeria monocytogenes is not classified as a spore-forming bacterium. Unlike spore-formers such as *Clostridium botulinum* or *Bacillus cereus*, which produce highly resistant endospores, *L. monocytogenes* lacks this survival mechanism. This distinction is critical for understanding its behavior in food processing and environmental persistence.
From an analytical perspective, the inability of *L. monocytogenes* to form spores significantly influences its survival strategies. Instead of relying on spores, it thrives in cold, moist environments, such as refrigerated foods, and can grow at temperatures as low as 1°C. This adaptability makes it a persistent challenge in food safety, particularly in ready-to-eat products like deli meats, soft cheeses, and smoked fish. Unlike spore-forming bacteria, which can survive extreme conditions like heat and desiccation, *L. monocytogenes* is more susceptible to pasteurization and cooking. However, its ability to survive in refrigerated conditions underscores the importance of proper food handling and storage practices.
Instructively, understanding that *L. monocytogenes* is not a spore-former has practical implications for food safety protocols. For instance, while spore-formers require high-temperature treatments (e.g., 121°C for 15 minutes in autoclaving) to ensure destruction, *L. monocytogenes* can be effectively eliminated by thorough cooking to an internal temperature of 74°C (165°F). Additionally, maintaining proper refrigeration below 4°C can slow its growth, though it will not completely eradicate the bacterium. Food processors should focus on preventing cross-contamination and implementing Hazard Analysis and Critical Control Points (HACCP) systems to mitigate risks.
Comparatively, the non-spore-forming nature of *L. monocytogenes* sets it apart from other foodborne pathogens like *C. botulinum*, which produces spores that can survive boiling. This difference necessitates tailored control measures. For example, while spore-formers may require multiple hurdles (e.g., heat, pH, and water activity control), *L. monocytogenes* control relies more on temperature management and sanitation. This distinction highlights the importance of pathogen-specific knowledge in designing effective food safety strategies.
In conclusion, the classification of *Listeria monocytogenes* as a non-spore-forming bacterium is a critical detail for food safety professionals and consumers alike. Its unique survival mechanisms and vulnerabilities inform targeted interventions, from cooking temperatures to refrigeration practices. By dispelling the misconception that *L. monocytogenes* forms spores, we can better address its risks and protect public health. Practical tips include avoiding cross-contamination, ensuring proper cooking temperatures, and adhering to "use-by" dates on refrigerated products. This knowledge empowers individuals and industries to combat this persistent pathogen effectively.
Bacillus Subtilis: Understanding Its Spore-Forming Capabilities and Significance
You may want to see also

Spore Formation Process: Does Listeria undergo sporulation like Bacillus or Clostridium?
Listeria monocytogenes, the bacterium responsible for listeriosis, does not form spores. This is a critical distinction from spore-forming pathogens like Bacillus and Clostridium, which can survive harsh conditions such as heat, desiccation, and chemicals by entering a dormant spore state. Listeria, in contrast, remains in a vegetative form, making it more susceptible to environmental stressors. Understanding this difference is essential for food safety protocols, as spore-forming bacteria require more aggressive control measures, such as high-temperature processing, compared to Listeria, which can often be controlled through proper refrigeration and sanitation practices.
The sporulation process in bacteria like Bacillus and Clostridium is a complex, multi-stage transformation triggered by nutrient deprivation. It involves the formation of a protective endospore that encapsulates the bacterial DNA and core enzymes, ensuring survival in adverse conditions. Listeria lacks the genetic machinery for this process, as it does not possess the sporulation-specific genes found in Bacillus and Clostridium. For instance, Bacillus cereus can form spores that withstand temperatures up to 121°C for 20 minutes, whereas Listeria is typically inactivated at 70°C for 1-2 minutes. This highlights the importance of tailoring food processing techniques to the specific pathogen in question.
From a practical standpoint, the inability of Listeria to form spores simplifies its control in food production environments. Unlike spore-formers, which may require multiple hurdles (e.g., heat treatment followed by refrigeration), Listeria can often be managed through single interventions. For example, maintaining temperatures below 4°C inhibits Listeria growth, whereas spore-formers like Clostridium botulinum require additional measures such as pH control (below 4.6) or modified atmosphere packaging. However, Listeria’s ability to grow at refrigeration temperatures underscores the need for vigilant monitoring and cross-contamination prevention.
Comparatively, the absence of sporulation in Listeria also influences its detection and eradication strategies. While spore-formers may require spore-specific assays (e.g., heat resistance tests), Listeria detection relies on standard culture methods or molecular techniques like PCR. In healthcare settings, Listeria infections are treated with antibiotics such as ampicillin (2 g every 4 hours) combined with gentamicin (1 mg/kg every 8 hours), whereas spore-forming pathogens like Clostridium difficile may necessitate specialized treatments like fecal microbiota transplantation. This underscores the importance of accurate pathogen identification for effective management.
In conclusion, while Bacillus and Clostridium leverage sporulation as a survival mechanism, Listeria’s inability to form spores shapes its behavior, control, and treatment. This distinction is pivotal for industries ranging from food production to healthcare, where targeted strategies are essential for mitigating risks. By understanding these differences, professionals can implement more effective and efficient measures to combat these pathogens, ensuring public safety and product integrity.
Vascular Plants: Exploring Reproduction via Spores and Seeds
You may want to see also

Survival Mechanisms: How does Listeria survive without forming spores?
Listeria monocytogenes, unlike many other bacteria, does not form spores—a common survival strategy in harsh conditions. Yet, it thrives in environments that would eliminate less resilient pathogens. This bacterium’s ability to persist without sporulation hinges on a combination of physiological adaptations and environmental exploitation. Understanding these mechanisms is critical for food safety, as Listeria’s survival tactics enable it to contaminate processed foods, refrigerated items, and even hospital settings.
One key survival mechanism is Listeria’s remarkable tolerance to extreme conditions. It can withstand temperatures as low as 0°C (32°F), allowing it to survive in refrigerated foods, where many other bacteria perish. This cold tolerance is attributed to its ability to maintain fluid cell membranes and produce cold-shock proteins that stabilize its cellular functions. Additionally, Listeria can endure high salt concentrations, often found in cured meats and cheeses, by accumulating osmoprotectants like glycine betaine, which balance internal osmotic pressure. These adaptations enable it to persist in food preservation environments designed to inhibit microbial growth.
Another critical factor is Listeria’s ability to form biofilms—structured communities of bacteria encased in a protective extracellular matrix. Biofilms provide a shield against sanitizers, antibiotics, and environmental stressors. In food processing facilities, Listeria biofilms can colonize surfaces like conveyor belts, drains, and equipment, serving as a persistent contamination source. Disrupting these biofilms requires rigorous cleaning protocols, including the use of quaternary ammonium compounds or chlorine-based disinfectants at concentrations of 200–400 ppm, coupled with mechanical scrubbing to remove the protective matrix.
Listeria’s intracellular lifestyle further enhances its survival. Once ingested, it can invade human cells by secreting proteins like internalin A and B, which allow it to penetrate the intestinal epithelium. Inside host cells, it replicates safely, evading the immune system and antimicrobial agents. This intracellular niche also protects it from external stressors, such as pH fluctuations and antimicrobial treatments. For instance, Listeria can survive in acidic environments like the stomach by entering cells and neutralizing pH stress through proton pumps.
Comparatively, while spore-forming bacteria like Clostridium botulinum rely on dormant spores to endure harsh conditions, Listeria’s survival is active and dynamic. Its ability to adapt metabolically, exploit protective niches, and resist environmental stresses underscores its uniqueness. For food handlers and health professionals, this means implementing targeted control measures: maintaining temperatures below 4°C (39°F) to slow growth, using vacuum packaging to limit oxygen exposure, and ensuring stringent hygiene practices to prevent biofilm formation. By understanding these mechanisms, we can more effectively combat Listeria’s persistence and reduce its impact on public health.
Creating Ant-Like Creatures in Spore: A Step-by-Step Guide
You may want to see also

Environmental Persistence: Can Listeria persist in harsh conditions without spores?
Listeria monocytogenes, the bacterium responsible for listeriosis, is notorious for its ability to survive in environments that would eliminate many other pathogens. Unlike spore-forming bacteria such as Clostridium botulinum, Listeria does not produce spores, yet it thrives in conditions that are cold, salty, or low in oxygen—environments often found in food processing facilities. This raises the question: How does Listeria persist without the protective advantage of spores?
One key to Listeria's resilience lies in its physiological adaptability. It can grow at refrigeration temperatures (as low as 1°C), a trait uncommon among foodborne pathogens. For instance, in a study published in the *Journal of Food Protection*, Listeria was detected on stainless steel surfaces in deli environments after 16 weeks at 4°C, despite regular cleaning. This cold tolerance allows it to survive in refrigerated foods like deli meats, soft cheeses, and smoked fish, which are often consumed without further cooking. Practical tip: To minimize risk, store perishable foods at or below 4°C and consume them within recommended timeframes.
Another factor in Listeria's persistence is its ability to form biofilms, slimy layers of bacteria that adhere to surfaces and protect the organism from sanitizers and disinfectants. Biofilms can develop on equipment in food processing plants, such as conveyor belts and drains, even in the presence of cleaning agents. A 2019 study in *Applied and Environmental Microbiology* found that Listeria biofilms could withstand quaternary ammonium compounds, a common sanitizer, at concentrations up to 200 ppm. To combat this, facilities should implement rigorous cleaning protocols, including periodic deep cleaning and inspection of hard-to-reach areas.
Listeria's resistance to osmotic stress further enhances its survival. It can tolerate high salt concentrations, often found in cured meats and brined foods, by synthesizing osmoprotectants like glycine betaine. This adaptation allows it to remain viable in products with salt levels up to 10%, though growth is typically inhibited above 5%. For consumers, this means that even foods preserved with salt may pose a risk if contaminated. Caution: Pregnant women, the elderly, and immunocompromised individuals should avoid high-risk foods like ready-to-eat deli meats unless thoroughly heated.
Comparatively, while spore-forming bacteria like Bacillus cereus can survive extreme conditions by forming dormant spores, Listeria relies on active metabolic strategies to endure harsh environments. This distinction highlights the importance of targeting Listeria's active cells through proper food handling and processing. For example, pasteurization and thorough cooking can effectively eliminate Listeria, but cross-contamination remains a risk in ready-to-eat products. Takeaway: Understanding Listeria's unique survival mechanisms is critical for developing effective control measures in both industrial and domestic settings.
Spore Syringe Shelf Life: Fridge Storage Duration Explained
You may want to see also

Food Safety Implications: Does Listeria's non-spore-forming nature affect food contamination risks?
Listeria monocytogenes, the bacterium responsible for listeriosis, is a non-spore-forming pathogen. Unlike spore-forming bacteria such as Clostridium botulinum, which can survive extreme conditions by forming highly resistant spores, Listeria relies on its ability to grow at refrigeration temperatures and tolerate high salt concentrations. This distinction significantly influences its food safety implications, particularly in ready-to-eat (RTE) products with extended shelf lives. For instance, while spores of Bacillus cereus can survive pasteurization, Listeria is more susceptible to heat treatment but can persist in refrigerated environments, posing a unique risk in cold-stored foods like deli meats, soft cheeses, and smoked fish.
The non-spore-forming nature of Listeria means it lacks the ability to enter a dormant, protective state under stress. However, its resilience in cold environments and ability to form biofilms on food processing surfaces make it a persistent threat. Unlike spore-forming bacteria, which require specific conditions to germinate and cause contamination, Listeria can actively multiply in refrigerated foods over time, even at temperatures as low as 1°C. This highlights the importance of stringent sanitation practices in food processing facilities, as cross-contamination from surfaces or equipment can introduce Listeria into products that bypass thermal processing steps.
From a risk management perspective, the non-spore-forming nature of Listeria shifts the focus to preventing contamination rather than eliminating spores. For example, in the dairy industry, pasteurization effectively kills Listeria cells, but post-processing contamination remains a critical concern. Food manufacturers must implement measures such as environmental monitoring, regular cleaning of equipment, and the use of antimicrobial packaging to mitigate risks. Consumers, particularly pregnant women, the elderly, and immunocompromised individuals, should adhere to safe food handling practices, such as consuming RTE products within recommended timeframes and storing them at or below 4°C.
Comparatively, the risks associated with non-spore-forming Listeria differ from those of spore-forming pathogens in terms of control strategies. While spore-forming bacteria may require high-temperature treatments or specific antimicrobials to ensure safety, Listeria control relies heavily on preventing growth and survival in the food supply chain. For instance, the FDA recommends that RTE meat and poultry products be consumed within 3–5 days of purchase to minimize Listeria risks. This contrasts with spore-forming pathogens, where risks are often mitigated through processes like canning or fermentation, which create conditions unfavorable for spore germination.
In conclusion, Listeria’s non-spore-forming nature necessitates a proactive approach to food safety, emphasizing contamination prevention and growth control. Unlike spore-forming bacteria, which pose risks primarily through their ability to survive harsh conditions, Listeria’s threat lies in its persistence in cold, nutrient-rich environments. By understanding this distinction, food producers and consumers can implement targeted strategies to reduce contamination risks, ensuring safer food products and protecting vulnerable populations from listeriosis.
Connect to Spore Players Without EA: A Step-by-Step Guide
You may want to see also
Frequently asked questions
No, Listeria monocytogenes, the species most commonly associated with listeriosis, is not a spore-forming bacterium.
While Listeria cannot form spores, it is highly resilient and can survive in a variety of environments, including refrigeration temperatures, which is unusual for non-spore-forming bacteria.
Listeria’s ability to survive in harsh conditions, such as low temperatures and high salt concentrations, is similar to some spore-forming bacteria, leading to confusion. However, it lacks the ability to form spores.







